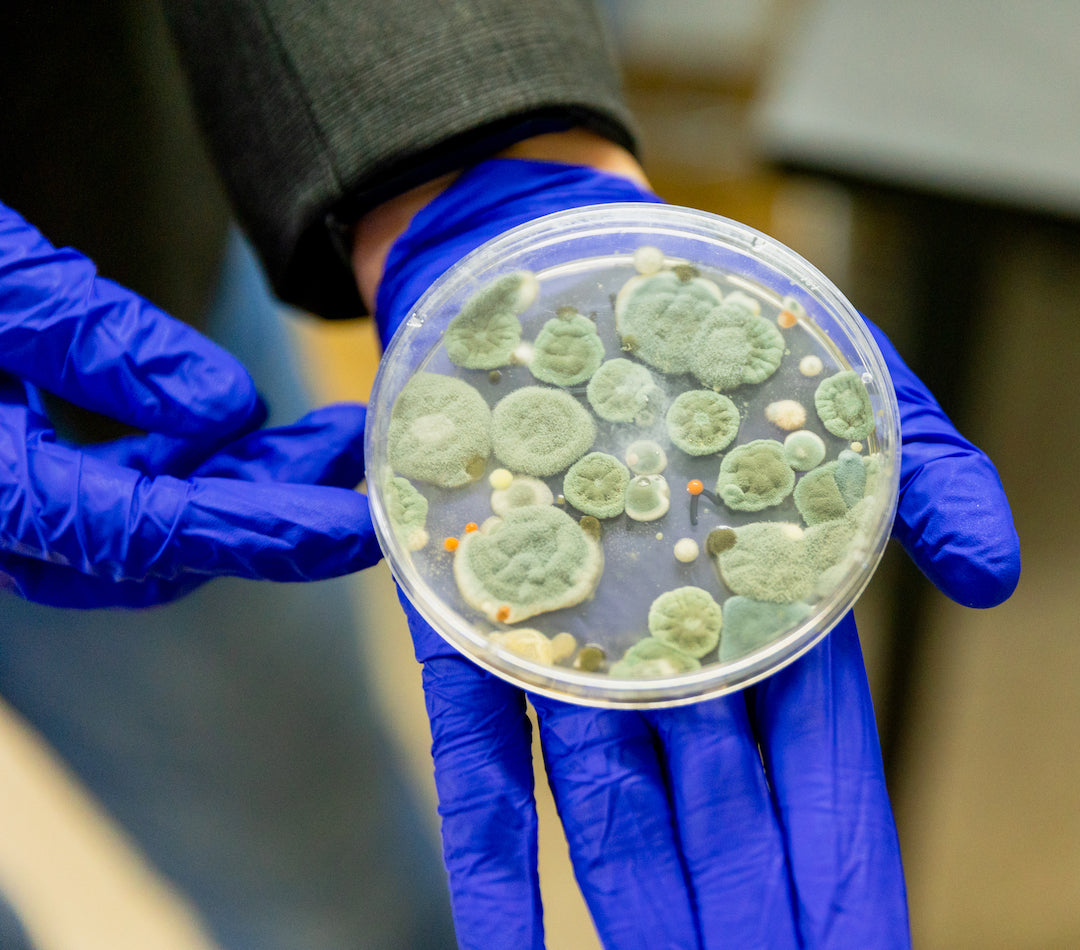
Eagle Protect - Derma² Nitrile Exam Gloves - Case (10 Boxes)

1
/
of
3
Eagle Protect - Derma² Nitrile Exam Gloves - Case (10 Boxes)
Eagle Protect - Derma² Nitrile Exam Gloves - Case (10 Boxes)
Regular price
$125.00 USD
Regular price
Sale price
$125.00 USD
Unit price
/
per
Couldn't load pickup availability
Eagle Derma² nitrile exam gloves are exceptionally soft and lightweight (3mil), yet durable and strong, ideal for medical use and precision and tactile work. They are LOW DERMA™ enhanced nitrile gloves for sensitive skin and for glove wearers prone to skin allergies and irritation. Eagle Derma² nitrile exam gloves are manufactured for protection against fentanyl and a wide range of chemicals. They are Delta Zero™ verified. Available in blue and black.
Specifications
- 200 Gloves per box, 10 Boxes per case (2,000 gloves total)
- LOW DERMA™ (Low Dermatitis Potential)
- Complies with USDA Organic Regulations
- 3mil thickness
- Textured fingertips for added grip
- Latex, PFAS, accelerant and powder free
- Medical Examination Grade (AQL 1.5)
- FDA (21 CFR 177) compliant for food handling
- FDA 510(k) cleared for medical use
- ASTM D6319
- ASTM F1671 Viral Penetration
- ASTM D6978 Chemotherapy Drug Tested - Tested against both Fentanyl and Gastric Acid (vomit) to simulate hazardous, overdose situations
- Made in a Certified WRAP Facility
- Halal and HACCP certified
- Available in blue and black